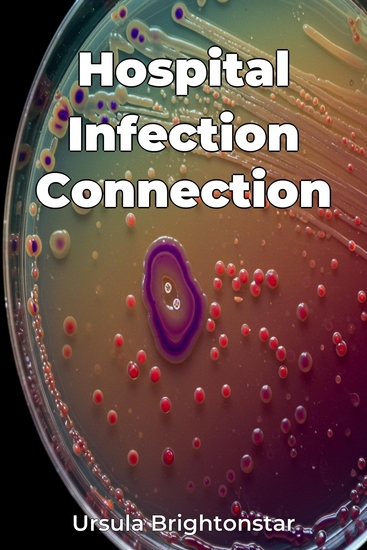

Hospital Infection Connection
Ursula Brightonstar
Tradutor A AI
Editora: Publifye
Sinopse
Hospital Infection Connection explores the surprising link between antibacterial detergents in hospitals and the rise of antibiotic-resistant bacteria, or "superbugs". It questions whether the prevalent use of these detergents, intended to combat infection, may inadvertently be fueling the problem. The book provides a comprehensive overview of how bacteria develop resistance, examining the impact of detergent use in hospitals and discussing potential, more effective strategies. The book reveals how antibacterial detergents exert selective pressure on bacterial populations, potentially driving the emergence of resistant strains, and challenges the assumption that "cleaner is always better." It argues for a more nuanced, evidence-based approach to hospital hygiene, integrating insights from infectious diseases, public health, and evolutionary biology. Beginning with the history of antibacterial use and the development of resistance, the book progresses across three sections: detailing the mechanisms of antibacterial agents, analyzing healthcare studies linking detergent use to resistant infections, and exploring alternative infection control strategies. It provides a balanced review of current practices to improve public health and offer pragmatic alternatives, making it a valuable resource for healthcare professionals and policymakers.














